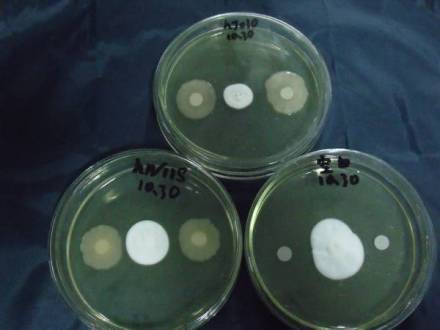

-
拮抗 编辑
拮抗是一种物质(或过程)被另一种物质(或过程)所阻抑的现象,包括代谢物间或药物间的拮抗作用。2种以上物质混合后的总作用小于每种物质分开来的作用之和也称为拮抗作用。
药物可解毒或可抵消处方中主药的副作用也称为拮抗作用,一种微生物活动而抑制或杀死另一种微生物也称拮抗作用。
中文名:拮抗
外文名:Antagonism
定义:一种物质被另一种物质所阻抑
包括:代谢物间或药物间的拮抗作用
实例:胰岛素与胰高血糖素
拼音:jié kàng
拮抗
拮抗
生理学中一种生理过程制约另一种生理过程也称拮抗作用。“拮”读作jié时,意为敲击或逼迫、欺压,“拮抗(作用)”正是此意的引申,因而在大部分词典中都找不到拮抗、拮抗作用或拮抗剂,《中国大百科全书》也未收录该词。
拮抗可以通过胰岛素与胰高血糖素对血糖含量的调节来说明。胰高血糖素是由胰岛A细胞分泌的,它的主要作用是促进糖原分解和非糖物质转化为葡萄糖,从而使血糖升高。而当血糖含量较高时,胰岛素分泌增加,胰高血糖素分泌减少,两种激素拮抗作用的结果是促进血糖合成为糖原,并抑制非糖物质转化为葡萄糖,使血糖的含量降低。当血糖含量较低时,胰高血糖素分泌增加,胰岛素分泌减少,结果是促使糖原分解为葡萄糖,并促使非糖物质转化为葡萄糖,使血糖含量升高。可见,胰岛素的降血糖作用与胰高血糖素的升血糖作用相互拮抗,共同实现对血糖代谢的调节,使血糖含量维持在相对稳定的水平。
拮抗加工原理
拮抗加工原理是由海林在18世纪晚期提出的。即所有的视觉体验产生于三个基本系统,每个系统包含两种拮抗成分:红对绿,蓝对黄,或者黑(没有颜色)对白(所有颜色)。
筛选有效抗生素
还有一种存在于生物间的拮抗作用,是指某种生物所产生的某种代谢产物可抑制其他种生物的生长发育甚至杀死他们的一种相互关系。在一般情况下,拮抗多指微生物间的“化学战术”,但有时因某微生物的生长而引起的其他条件改变(如缺氧、pH改变等)抑制其他种生物的现象也称为拮抗。例如,在制造泡菜、青贮饲料过程中的乳酸杆菌,就是由于它能产生大量乳酸而抑制其他腐败微生物生长发育的。但微生物间最典型、对人类关系最密切的拮抗作用,当推微生物所产生的能抑制其他生物生长发育的抗生素。微生物间的拮抗关系可为抗生素的筛选、食品保藏、医疗保健和动植物病害的防治等提供很多有效的手段。
1、本站所有文本、信息、视频文件等,仅代表本站观点或作者本人观点,请网友谨慎参考使用。
2、本站信息均为作者提供和网友推荐收集整理而来,仅供学习和研究使用。
3、对任何由于使用本站内容而引起的诉讼、纠纷,本站不承担任何责任。
4、如有侵犯你版权的,请来信(邮箱:baike52199@gmail.com)指出,核实后,本站将立即删除。






























